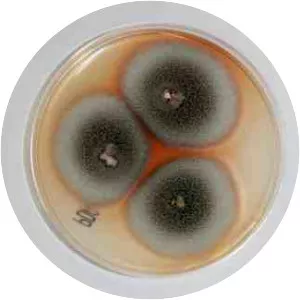
Thermomyces -

Thermomyces Lanuginosus
| Use attributes for filter ! | |
| Scientific name | Thermomyces lanuginosus |
|---|---|
| Order | Eurotiales |
| Rank | Species |
| Date of Reg. | |
| Date of Upd. | |
| ID | 2379991 |
About Thermomyces Lanuginosus
Thermomyces lanuginosus is a species of thermophilic fungus that belongs to Thermomyces, a genus of hemicellulose degraders. It is classified as a deuteromycete and no sexual form has ever been observed.